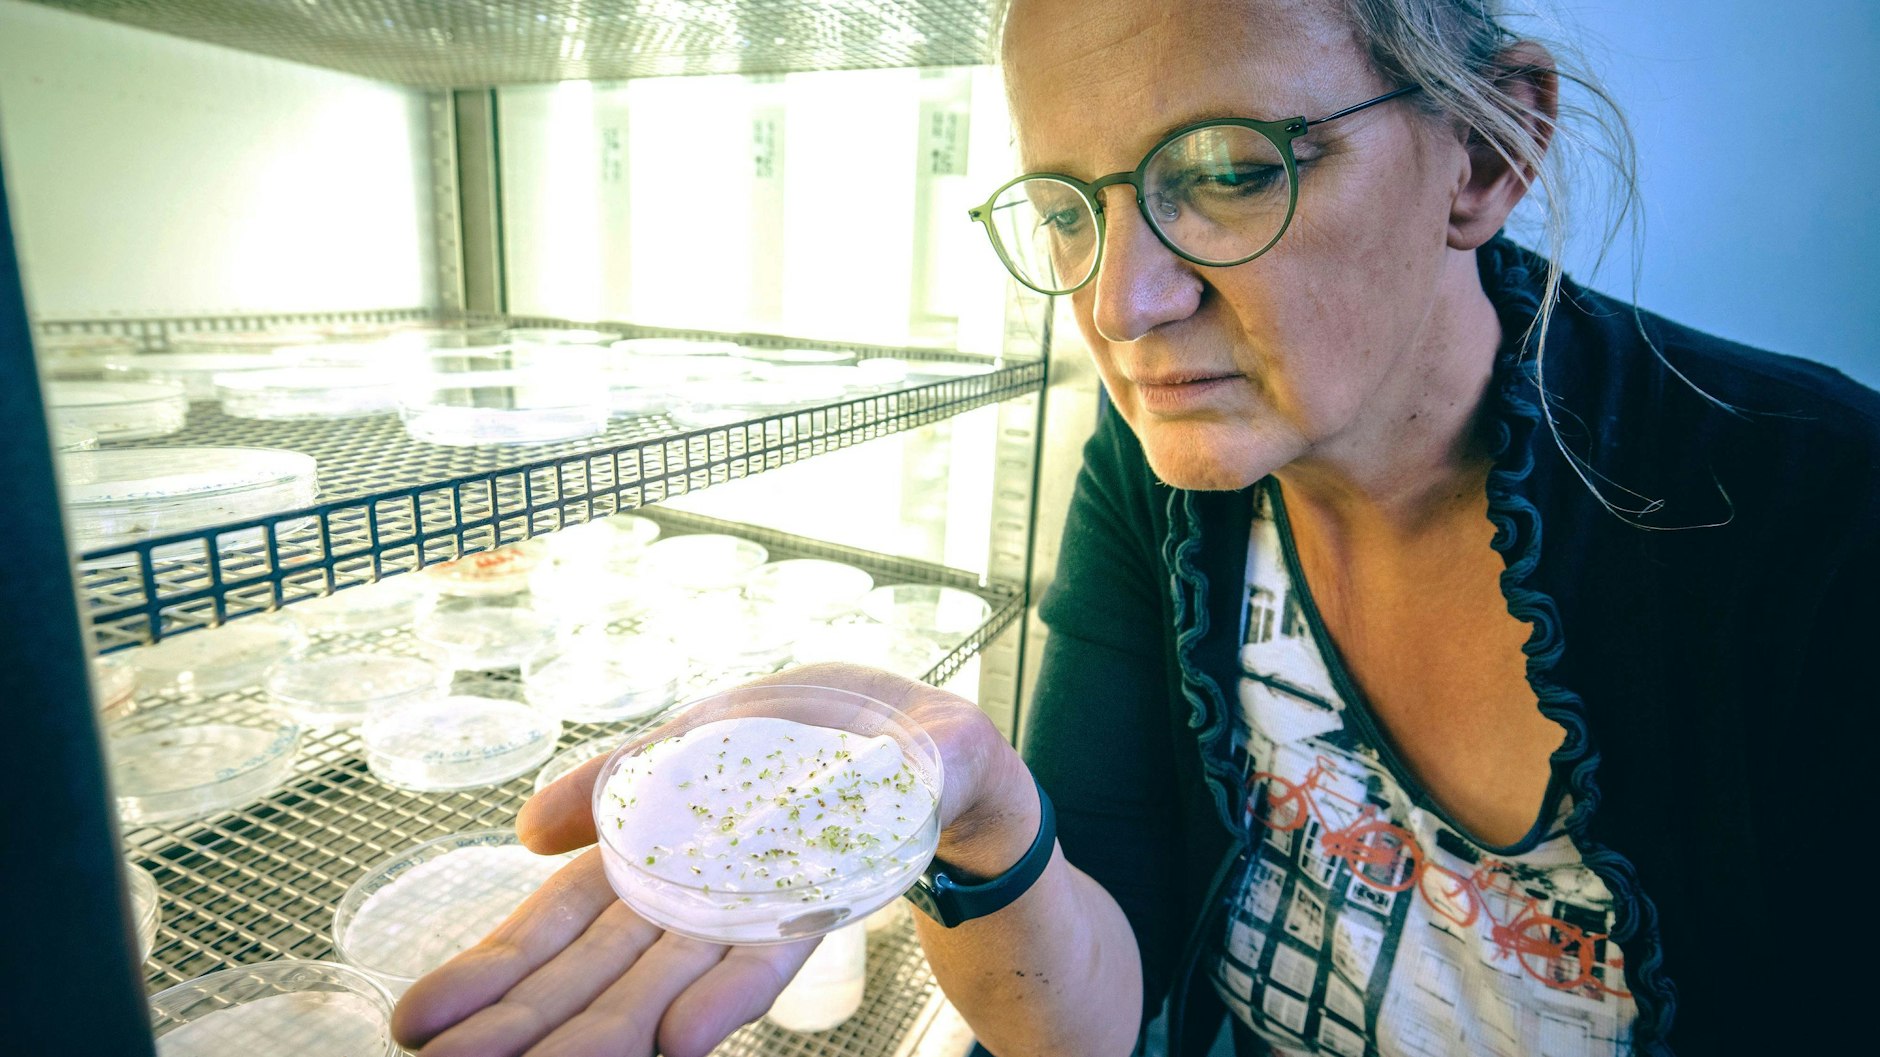
Die Biologin Silvia Oevermann blickt in ihrem Labor in den Keimschrank.

Wo Wanderer den Blick in das Tal gleiten lassen, über Wiesen und Felder, sind Peter Borgmann und Silvia Oevermann meist gebückt auf der Suche nach Seltenheiten. Die beiden Wissenschaftler sammeln Samen von Wildpflanzen, die vom Aussterben bedroht sind. Samen, die für die Zukunft gerettet werden und in den Botanischen Gärten, auch in Berlin, eingelagert werden. „Das Sammeln und die Einlagerung von Wildpflanzensamen ist wie eine Lebensversicherung für eine Art oder Populationen“, sagt Peter Poschlod von der Universität Regensburg.
Schmale Trampelpfade durchziehen das offene Grasland am sonnenbeschienenen Südhang des Silberbergs. Das auf den ersten Blick unscheinbare Naturschutzgebiet in Hagen am Teutoburger Wald ist eine Schatzkammer für Botaniker und Pflanzenliebhaber. Zwischen Wiesenhafer, Fiederzwenke und anderen Gräsern entdeckt Peter Borgmann in einer schattigen Senke die erste zartgelb blühende Attraktion: „Das Galmei-Veilchen, Viola calaminaria, eine der seltensten Pflanzen Deutschlands“, sagt der Biologe vom Botanischen Garten der Uni Osnabrück.
Lesen Sie auch: Greenpeace rechnet vor: So ist das 9-Euro-Ticket auch weiterhin finanzierbar! >>
„Weil es an schwermetallhaltige, magere Böden angepasst ist, kann es in diesem ehemaligen Erzabbaugebiet wachsen.“ Die wilde Verwandte des Stiefmütterchens komme sonst nur noch im Raum Aachen vor. Borgmanns Kollegin Silvia Oevermann hockt derweil schon mit einem Papiertütchen vor den kaum 20 Zentimeter aufragenden feingliedrigen Pflanzen.

Lesen Sie auch: Horoskop für Freitag, den 22. Juli 2022: So wird Ihr Tag heute – laut Ihrem Sternzeichen >>
Behutsam streicht sie die Blätter zur Seite, findet aber nur wenige Samenkapseln. „Da müssen wir wohl noch einmal wiederkommen“, sagt Borgmann. Die beiden Wissenschaftler sammeln vornehmlich im Sommer und Herbst vom Sauerland bis nach Schleswig-Holstein die Samen vom Aussterben bedrohter Wildpflanzen, um sie zu bewahren, wieder anzusiedeln und die Populationen zu stützen.
Botanischer Garten in Berlin macht mit
Das Bundesumweltministerium fördert das Projekt „Wildpflanzenschutz Deutschland“ (WIPs-De) bereits seit 2013. Die Botanischen Gärten in Osnabrück, Regensburg, Berlin, Potsdam und Mainz haben Deutschland in vier Projektregionen aufgeteilt. „Das Sammeln und die Einlagerung von Wildpflanzensamen ist wie eine Lebensversicherung für eine Art oder Populationen“, sagt Projektleiter Peter Poschlod von der Universität Regensburg.
Lesen Sie auch: Wärme-Rekorde purzeln und am Sonntag kommt der Hitzepeak 2.0>>
Die Samen könnten über Jahrzehnte, wahrscheinlich sogar Jahrhunderte keimfähig bleiben, erklärt der Professor für Ökologie und Naturschutzbiologie. Das Projekt kümmere sich um 92 seltene Wildpflanzenarten, für die Deutschland eine besondere Verantwortung habe, die also ausschließlich oder schwerpunktmäßig in Deutschland vorkommen. Sogenannte Verantwortungsarten sind etwa das zierliche Wollgras, die Purpur-Grasnelke, der Zwerglerchensporn oder das Bayerische Löffelkraut.
Landwirtschaft setzt Wildpflanzen stark zu
Vor allem die Landwirtschaft, die Stickstoff in die Atmosphäre bringe und somit quasi kontinuierlich dünge, setze vielen Wildpflanzen zu, sagt Poschlod. Dadurch verarmten die Pflanzenbestände. „Die höchste Artenvielfalt findet sich bei uns auf mageren Standorten.“ Der Klimawandel werde künftig ein Übriges zum Artenverlust beitragen.
Lesen Sie auch: UPDATE! Flugfaul und stechfreudig: Die Asiatische Tigermücke ist in Berlin gelandet – SO erkennen Sie das gefährliche Insekt>>
Wenn Saatgut eingelagert werde, bleibe auch die genetische Vielfalt erhalten, erklärt Poschlod: „Wir wissen noch nicht über alle Wildpflanzen Bescheid, ob sie nicht irgendwelche Schätze enthalten, wie etwa medizinisch wirksame Substanzen.“
Samen werden im Botanischen Garten eingefroren
Um sie zu bewahren, werden die zuvor begutachteten und getrockneten Samen bei minus 18 Grad Celsius in Kältekammern der beteiligten Gärten eingelagert. Zur Sicherheit schicken die Wissenschaftlerinnen und Wissenschaftler von jeder Probe einige Samen an den Botanischen Garten Osnabrück, so dass im dortigen Kühlhaus der gesamte Bestand verfügbar ist.
Lesen Sie auch: Mutter lässt Tochter (18 Monate) sechs Tage alleine zu Hause – tot! >>
Biologin Silvia Oevermann zieht die schwere Tür auf und taucht in den strengen Frost ein. Auf schmucklosen Metallregalen reihen sich Kästen und Kartons aneinander, in denen Tausende von Aluminiumtüten stecken. Darin befinden sich, vakuumiert und vor Licht geschützt, die Samenproben. Oevermann zieht eine Tüte hervor: „Anthericum liliago - Trauben-Graslilie“ steht darauf. Die Samen wurden 2021 am Edersee in Hessen gesammelt, zeigt ein QR-Code.
Zurück in der angenehmen Wärme des Sommers begutachten Oevermann und Borgmann die Fortschritte im Keimschrank. Dort werden die Samen auf Keimfähigkeit getestet. Einige werden später in Töpfe oder Beete auf dem Gelände des Gartens gepflanzt. Mit diesen sogenannten Erhaltungskulturen sorgen alle Gärten dafür, dass gefährdete Arten außerhalb ihrer natürlichen Standorte überleben.
Seltene Pflanzen werden renaturiert
Einige werden in geeigneten Regionen ausgewildert. Borgmann postiert sich vor einem Areal mit Dutzenden von Arnika-Jungpflanzen, die in Plastiktöpfen auf den Transport in ihren neuen Lebensraum warten. „Die sind für den Harz vorgesehen“, erklärt der Botaniker. Auf solche Renaturierungsaktionen freut er sich besonders.
Lesen Sie auch: Das ist die beste Zahnpasta für Kinder: Und die besten Tipps und Tricks, damit Ihr Kind gern die Zähne putzt!>>
Mit Sorge blickt der Experte allerdings auf das Ende des bereits einmal verlängerten Projekts im Sommer 2023. Er vermisst eine Strategie hinter dem Sammeln von Saatgut in Genbanken: „Es ist nicht geklärt, was langfristig mit den Samen passiert und wie es weitergeht.“ Seiner Ansicht nach müssten Saatgutgenbanken dauerhaft finanziert werden: „Wir haben schließlich erst einen Bruchteil der gefährdeten Arten gesammelt.“

Projektleiter Poschlod moniert ein Hin- und Herschieben der Verantwortung. Der Bund habe sich im Rahmen internationaler Abkommen dazu verpflichtet, 75 Prozent der gefährdeten Arten in Saatgut-Sammlungen für Renaturierungsprojekte vorzuhalten. „Das sind unabhängig von den 92 Verantwortungsarten ein Vielfaches mehr an Arten.“ Zugleich verweise der Bund aber darauf, dass Naturschutz laut Gesetz Ländersache sei.
